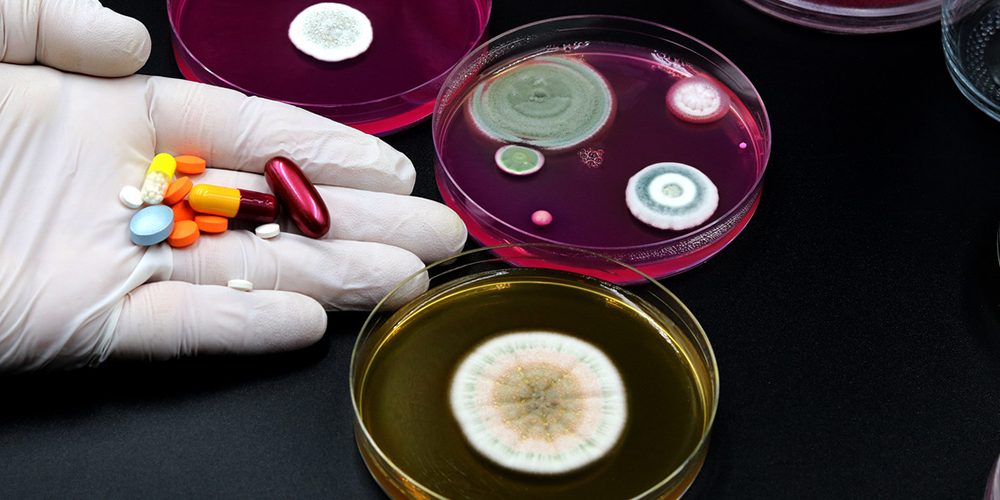
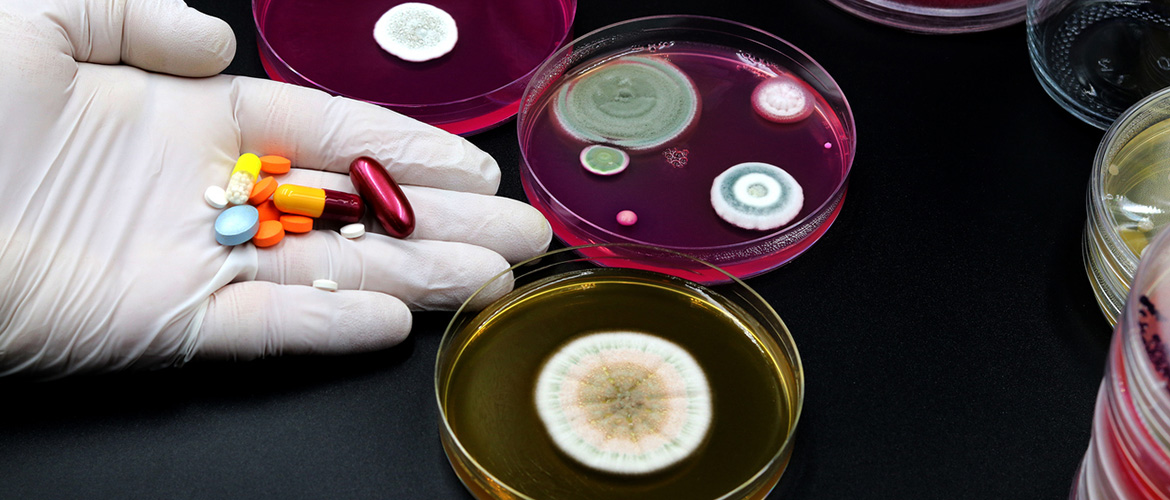

Antimicrobial Stewardship in Assisted Living: Engaging Residents and Families
By Nicole Barnett, PharmD, BCGP
Antimicrobial resistance is a growing global concern, and its effective management requires a comprehensive approach that includes not only healthcare professionals but also the active involvement of residents and families in long-term care and senior living settings.
With 30 to 70% of emergency department (ED) visits being potentially avoidable, and up to 1 in 4 antibiotics ordered for older adults during an ED visit prescribed inappropriately, it becomes crucial for everyone involved to understand their role in antimicrobial stewardship.
While physicians, pharmacists, and community staff work hard to be good stewards of appropriate antimicrobial use, and processes are in place to help reduce unnecessary antibiotic use in LTC, residents’ families have a significant influence on care. They may be insistent an antimicrobial be prescribed, or their family member be sent to the ED. Families may go as far as calling the provider or even 911 to initiate potentially unnecessary lab tests and antimicrobial orders. In certain situations, it may feel as if the care team in the community no longer has the ability to make an impact on antimicrobial use. To empower the care team, let’s take a look at some key talking points to help residents and family members play a more active role in preventing unnecessary antimicrobial use.
First, the data analytics and insights provided by GuardianShield’s Antimicrobial Stewardship program can help communities identify areas of concern and opportunity when it comes to antibiotic use. This information can serve as a starting point for conversations with families.
We should not wait to have the initial conversation about the role each member of the care team plays in antimicrobial stewardship until a situation arises, but discuss it upon admission and during each care conference. The more residents, families, and caregivers hear about responsible antimicrobial use, the more this way of thinking will become their standard. Repetition is key.
As our population ages, there is a movement to help shift the way we approach care of individuals in advanced age using an age-friendly lens. The Institute of Healthcare Improvement has collaborated with other organizations to design the 4Ms Framework which focuses on what Matters to the individual and caregivers, and how areas of Medication, Mentation and Mobility can align with what matters. How can we use the 4Ms framework to help support antimicrobial stewardship efforts?
Identify what Matters: Know and align care with each older adult’s specific health outcome goal. Specific to antimicrobial use, ED visits and hospitalizations, questions may include:
- How do you feel about taking an antibiotic?
- How do you feel about NOT taking an antibiotic?
These questions allow you to get to the root of what matters regarding the treatment of potential infections. It also helps to establish their level of health literacy in order to tailor the conversation to optimize understanding.
Once what matters to the resident and caregiver has been identified, it is helpful to direct the conversation towards providing education on why we are concerned about the overuse of antimicrobial therapy.
Basic areas of education should include:
What does it mean to be colonized vs infected?
Dr. John Millard, program manager of infectious diseases for the Veterans Affairs Northwest Network, discusses antibiotics being the greatest discovery of all time, extending the average lifespan by 23 years. Bacteria are everywhere, and when certain bacteria are present, they can either colonize or infect individuals. When bacteria are resent but does not cause disease, this is considered colonization. When bacteria are present and the body does not have an adequate defense to fend off disease, this becomes an infection.
What is the difference between a virus and bacteria? What are antibiotics?
Antibiotics are used to kill bacteria, while antivirals treat viruses. Bacteria are free-living cells that can live on their own outside of the body, unlike viruses, that need a living source to survive.
Why are we concerned about using antibiotics when they are not needed?
Antibiotics are drugs and like any other drugs, they carry serious risks particularly for patients >65 years including allergic reaction, drug-drug interaction, delirium, cardiac arrhythmias and Clostridioides difficile infection in addition to antibiotic resistance.
Bacteria are smart and will mutate to survive despite the presence of an antibiotic in which it had already been exposed. Dr. Millard emphasizes that in certain situations, inappropriate antibiotic use can be like giving bacteria steroids, driving resistance.
However, as identified above, resistance is not our only concern. Patients and caregivers have been found to have a better understanding of antibiotic risks when the risks are described in a more personal way.
A team of researchers at Johns Hopkins School of Medicine identified multiple statements that helped reduce patient request for a potentially unnecessary antibiotic including:
- Taking antibiotics can hurt your body’s natural defenses. This makes it easier for you to get another infection.
- By changing your normal gut bacteria, antibiotics can cause allergies, asthma and stomach problems.
- Antibiotics can cause bad bacteria to overgrow in your gut. This can cause diarrhea and belly pain.
They found a more favorable response was received when discussion focused on potential harm to self or caregivers, versus potential harm to society which typically focused on antibiotic resistance. This further highlights the discussion should be tailored to the patient and what matters to them.
Finally, to support the above efforts, it is important to ensure the resident and family understand monitoring of symptoms will be completed in order to provide appropriate care. This should also include alternative treatments that can be provided for symptom management including increased hydration, short course antihistamine, acetaminophen for pain, guaifenesin, or cough suppressant for cough/congestion, etc., depending on presentation.
Allow caregivers and residents opportunity to express any questions or concerns about antimicrobial use and bring it back to what matters to them. Include the resident and caregivers as integral parts of the care team. Rely on the expertise of the senior care pharmacist, and remember that each member of the resident’s care team has a role in supporting responsible antimicrobial use.
Available resources:

Nicole Barnett, PharmD, BCGP – Consultant Pharmacist
Nicole Barnett is a Board-Certified Geriatric Pharmacist and clinical consultant at Guardian Pharmacy of Minnesota with over 15 years’ experience promoting the health and well-being of our aging population. With focus on age-friendly care, Nicole specializes in medication deprescribing and optimization with a growing passion in the area of pharmacogenomics.